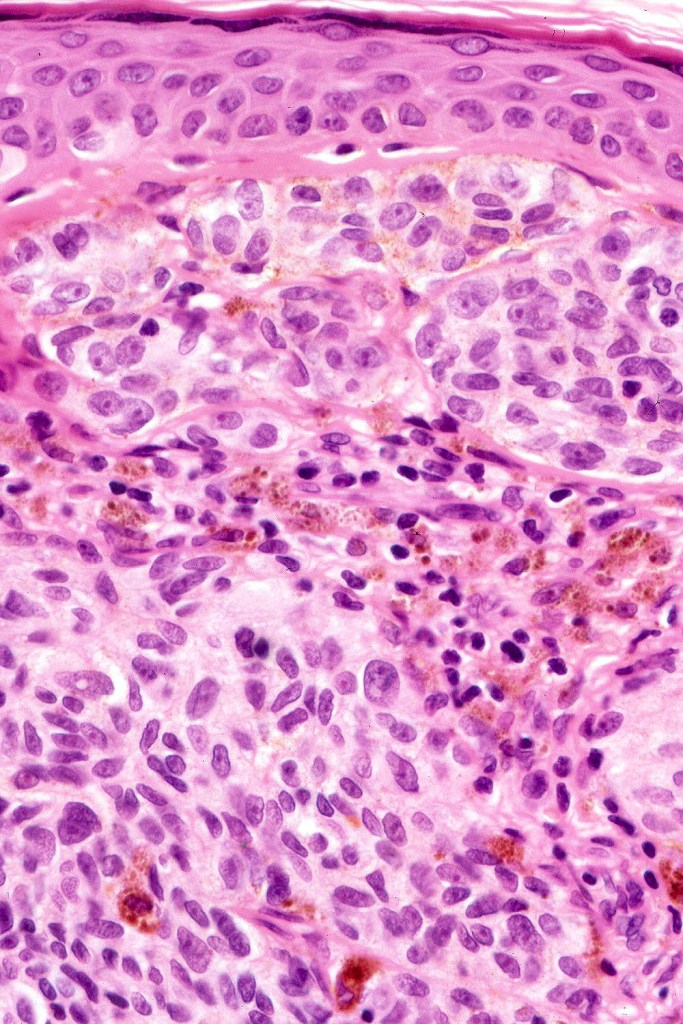
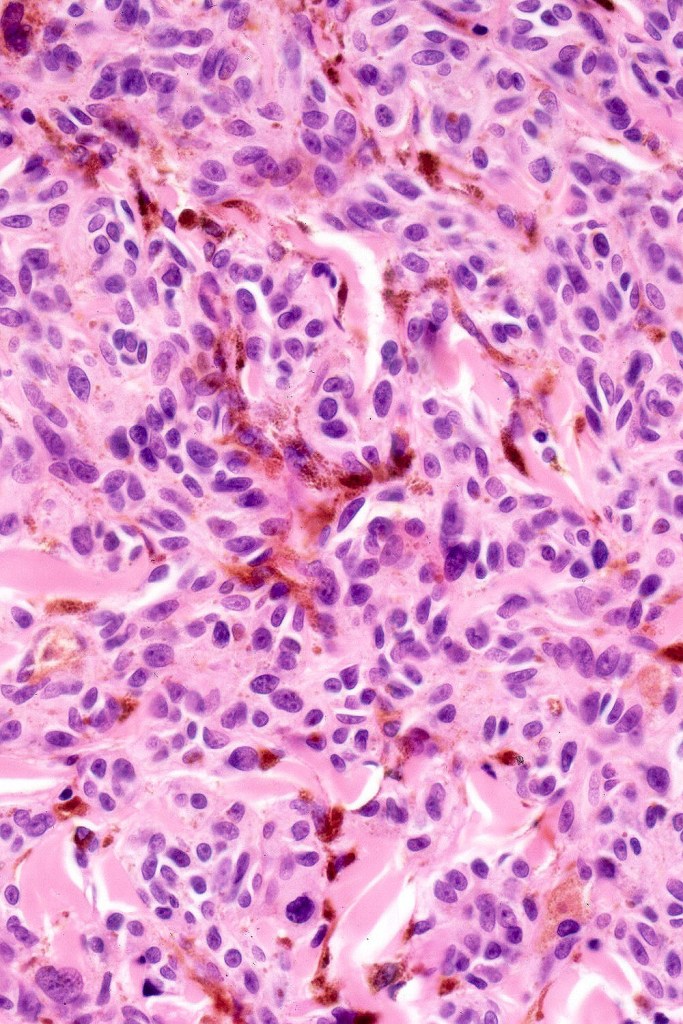
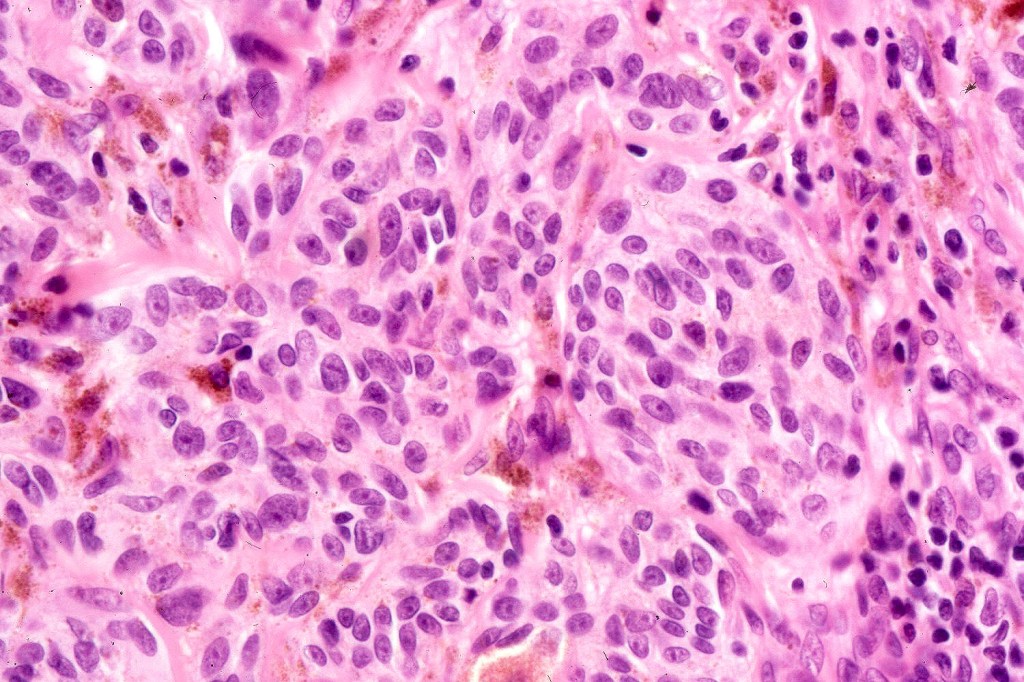
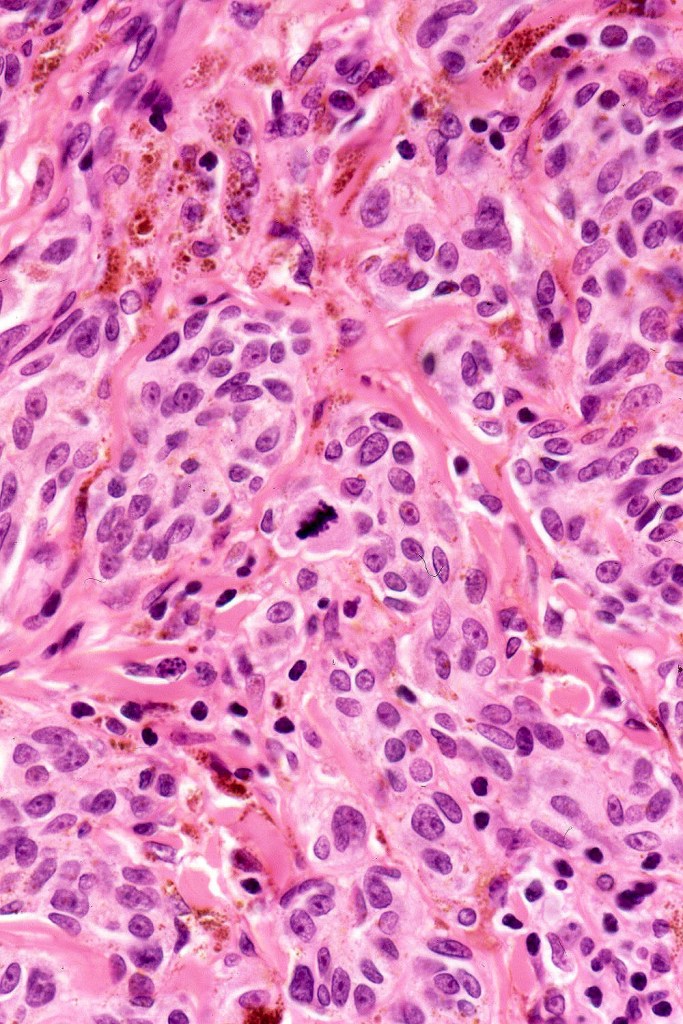
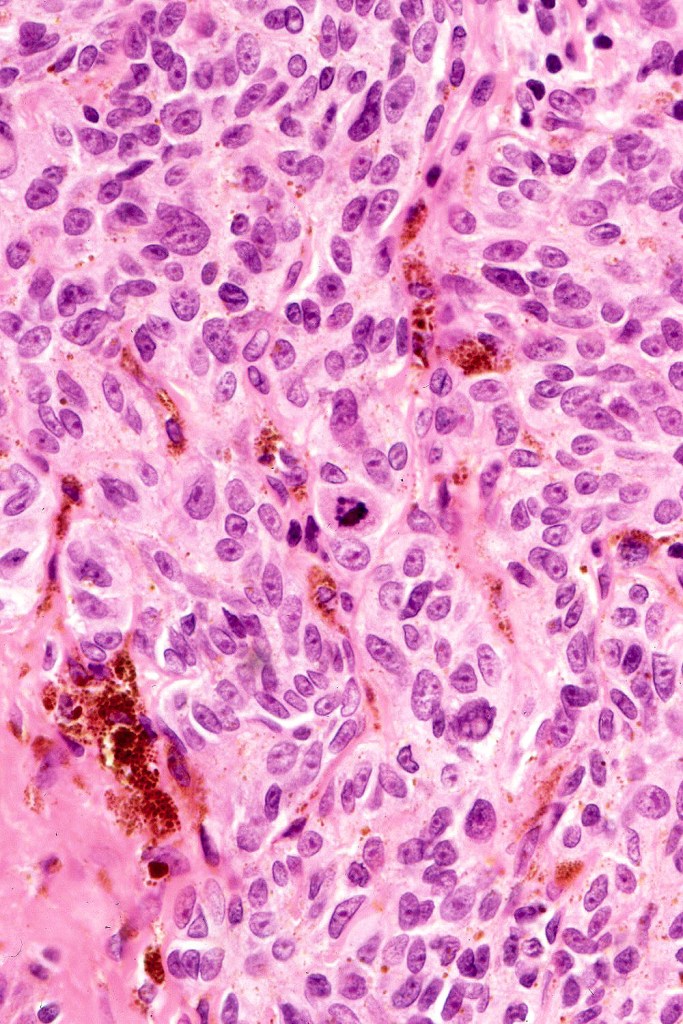
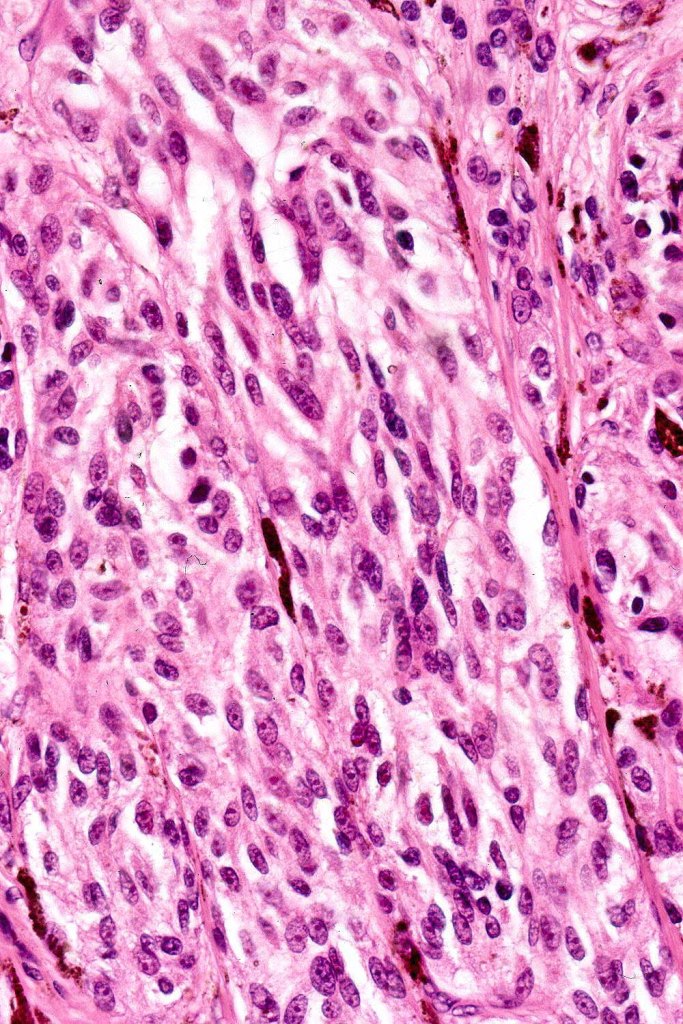
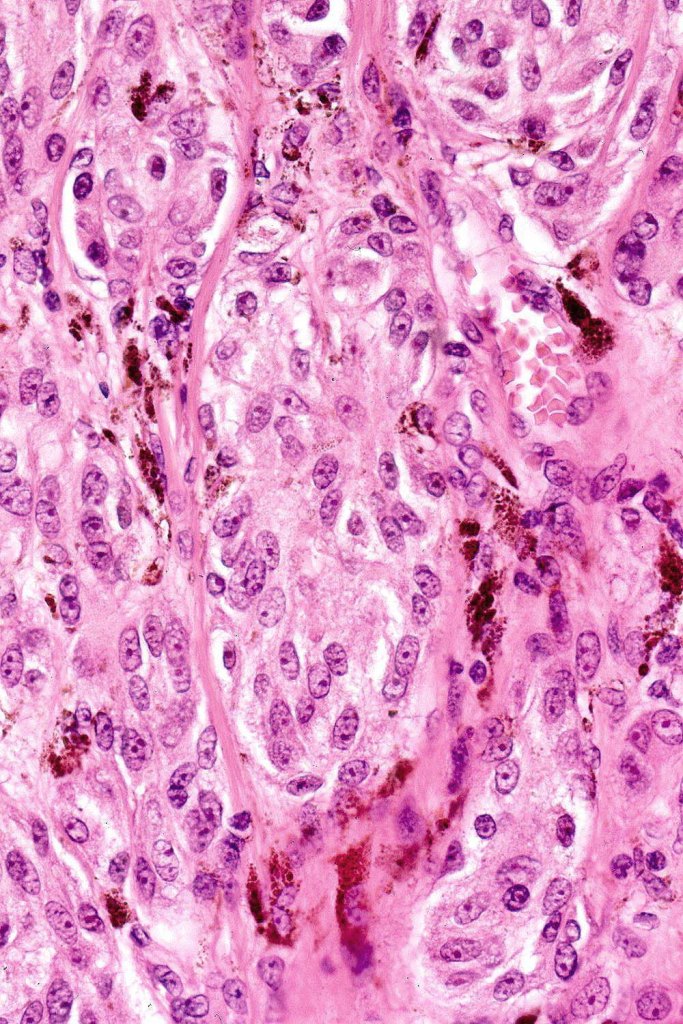
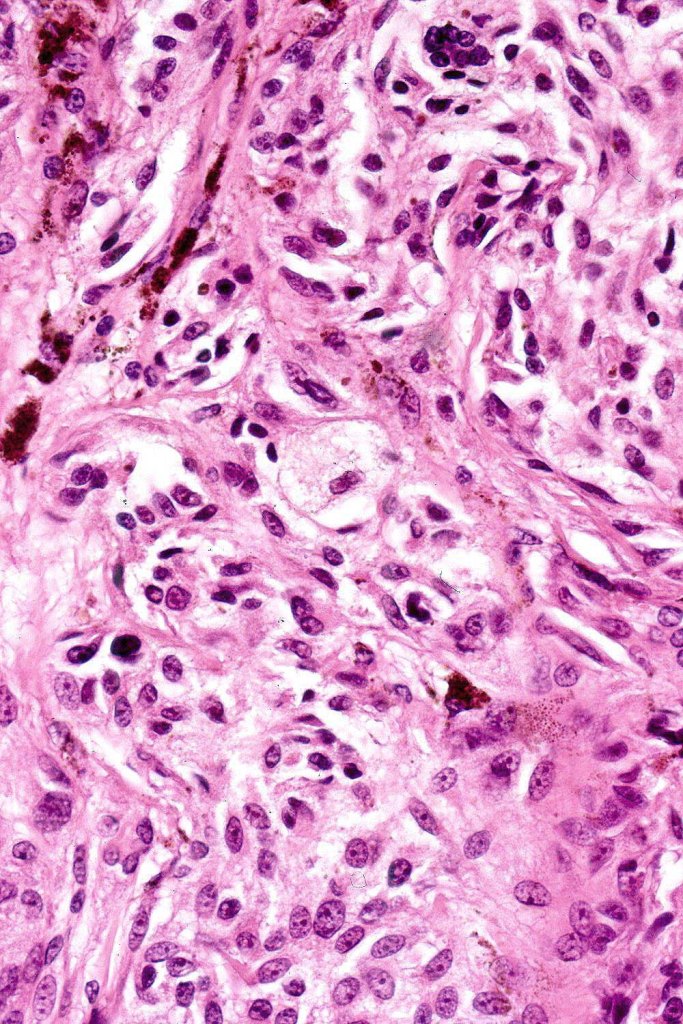
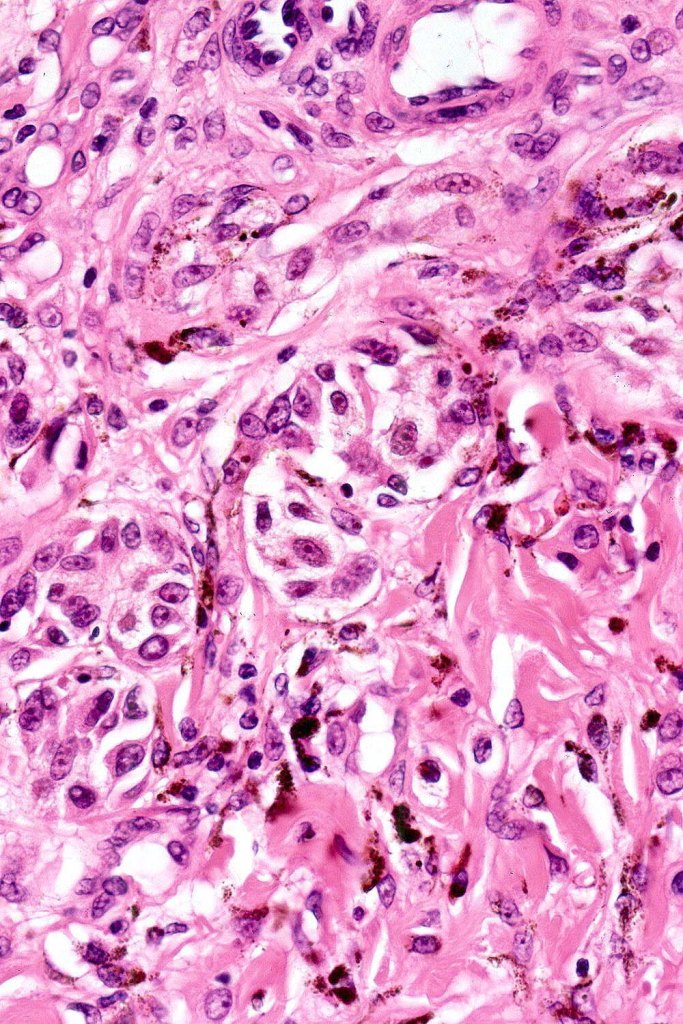
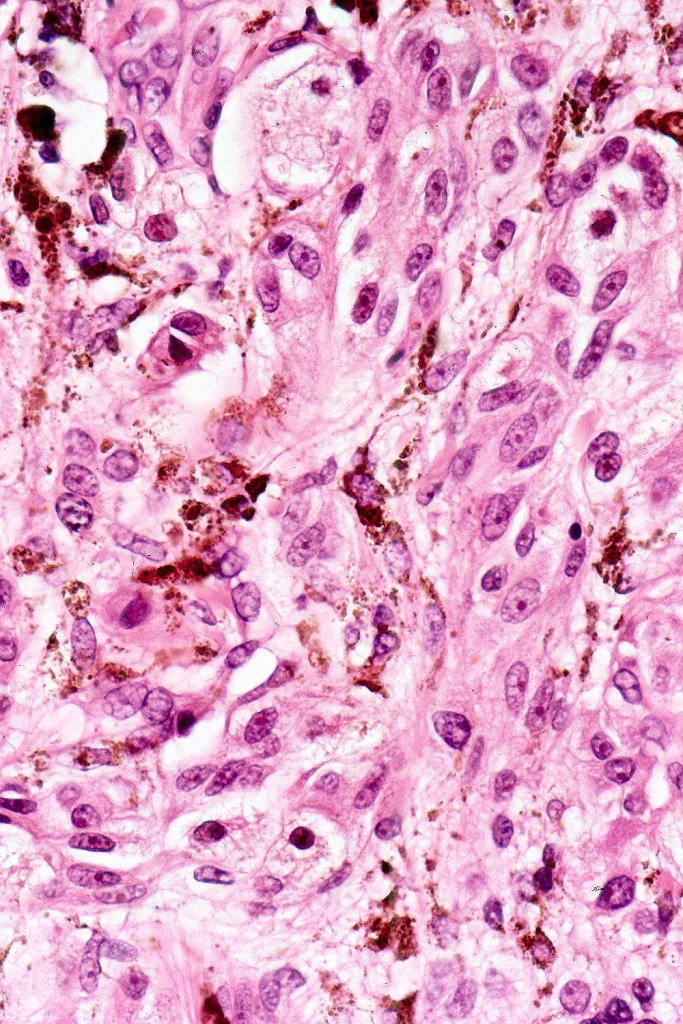
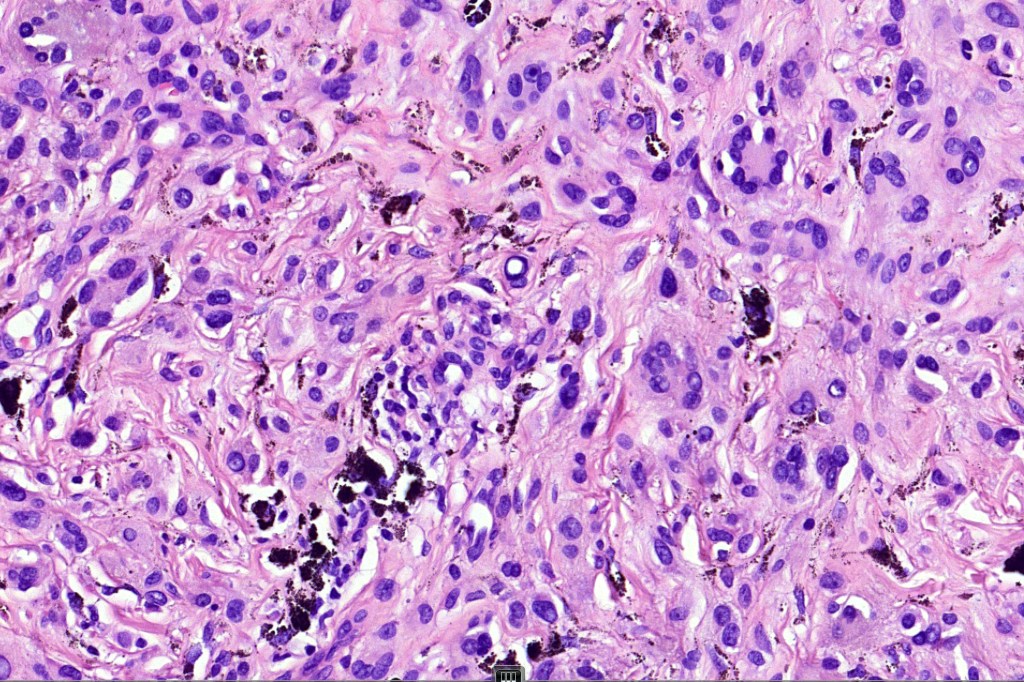

A generally benign pigmented melanocytic nevus which may uncommonly be associated with recurrence and which exceptionally can be associated with lymph node involvement but no visceral spread. There are a small number of cases where such atypical variants have developed systemic spread (plexiform melanoma)
Clinical features
•Irregular up to 1.0 cm diameter dark brown or black papule or nodule
•0.2-1.0 cm diameter
•Young adults- 2nd & 3rd edcade (age range 1-77 years)
•M=F
•Head & neck, back, extremities
•Recurrences rare
•Malignant variant (exceptionally rare)
Histological features
•Sometimes combined lesion (with a banal nevus, exceptionally Spitzoid elements)
•Symmetrical, circumscribed wedge-shaped infiltrate-most common growth pattern with the broad base uppermost, deeper aspect extends along appendageal structures & neurovascular bundles with a fasciular or plexiform pattern
•Plexiform growth pattern very occasionally seen (plexiform spindle cell nevus (Barnhill)
•Superficial epithelioid cells
•Deep spindle cells
•Focal atypia (enlarged, hyperchromatic nuclei)
•Clear cells
•Dendritic cells
•Melanophages
•Multinucleate giant cells
• Cytoplasmic intranuclear pseudo-inclusions, small eosinophilic nucleoli
•Occasional mitoses
. Perineural spread sometimes seen, infiltration of arrector pili muscles common
Atypical features which may be encountered include marked nuclear pleomorphism, conspicuous mitotic activity, atypical mitoses (atypical or borderline lesion)- may be associated with lymph node involvement although frank maliganncy is exceptional

Immunohistochemistry & molecular data
•Strong nuclear & cytoplasmic expression of β catenin, cyclin D1 & LEF1
•S100 & HMB45 +ve
•BRAF V600E +ve (particularly combined variants)
•P16 +ve
•Ki67 very low
•PRAME –ve
•WNT pathway activated usually through gain of function mutations of CTNNB1
•MAPK gene mutations such as BRAFV600E, MAP2K1 & HRAS

Leave a comment